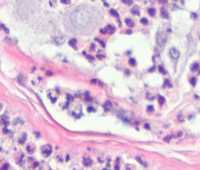

您现在的位置是:戴恩生育公司 > 广州代生供卵试管 >
2026广州试管代怀孕价格行情与供卵代怀公司介绍
2025-08-22 14:45广州代生供卵试管 944人已围观
简介2026广州试管代怀孕价格行情与供卵代怀公司深度解析 随着医疗技术的飞速发展,广州作为华南地区的医疗中心,其辅助生殖技术始终走在全国前列。步入2026年,随着生育政策的演变与社会观念的开放,越来越多的家庭开始关注如何通过高科技手段实现优生优育。本文将从价格行情、服务模式、机构管理及风险防控等多个维...
2026广州试管代怀孕价格行情与供卵代怀公司深度解析
随着医疗技术的飞速发展,广州作为华南地区的医疗中心,其辅助生殖技术始终走在全国前列。步入2026年,随着生育政策的演变与社会观念的开放,越来越多的家庭开始关注如何通过高科技手段实现优生优育。本文将从价格行情、服务模式、机构管理及风险防控等多个维度,为您深度解析广州市场的现状。
一、 2026年广州辅助生殖市场概况与政策背景
1. 技术普及与市场转向
到2026年,广州的辅助生殖市场已完成从“解决不孕”到“优生优育”的战略转型。三代试管技术(PGD/PGS)在广州各大生殖中心已实现高度普及,不仅用于解决染色体异常问题,更成为阻断遗传疾病、提升胚胎着床率的核心手段。尽管医保政策已部分覆盖常规试管费用,但针对高端定制化需求,市场仍由社会化服务机构补充。
2. 法律边界与合规化探索
虽然《人类辅助生殖技术管理办法》严禁商业化操作,但市场需求催生了大量灰色地带。2026年的行业趋势是“服务外包化”与“流程透明化”。客户在选择服务时,越来越倾向于寻找能够提供法律规避方案与财务安全保障的专业中介,而非单纯的地下诊所。
二、 2026广州试管及代怀价格行情深度解析
1. 常规技术与增值服务收费
在广州,常规试管婴儿的费用结构已相对透明。第一、二代技术主要针对基础不孕,而三代试管则因涉及胚胎筛查,成本显著增加。以下是2026年广州市场主流收费参考:
| 技术类别 | 基础医疗费 | 核心差异项 | 预计总支出 |
|---|---|---|---|
| 第一/二代试管 | 3万 - 5万 | 促排药、取卵、移植 | 5万 - 8万 |
| 第三代试管 (PGT) | 6万 - 10万 | 胚胎遗传学筛查 (按个收费) | 12万 - 18万 |
| 供卵/借卵方案 | 8万 - 12万 | 志愿者补偿、筛选费 | 15万 - 25万 |
2. “包成功”套餐的逻辑陷阱与现实
市场上盛行的包成功套餐,2026年的行业标准通常设定在60万至80万人民币之间。这类套餐通常包含多次促排、多次移植以及孕期管理费用。其核心逻辑在于:如果两年内未抱到健康宝宝,机构将扣除已发生的第三方支出后退还余款。这要求客户的精子活力与基础卵泡数必须达到机构设定的门槛。
三、 供卵(借卵)服务的运作现状与资源获取
1. 渠道差异:公立 vs 私立
公立医院的供卵渠道依然面临“一卵难求”的局面,排队周期通常在2年以上。相比之下,广州本地的助孕公司通过建立庞大的志愿者档案库,可将匹配周期缩短至2-4个月。2026年,这些机构已实现数字化筛选,客户可通过视频面试、学历认证等方式精准匹配志愿者。
2. 志愿者筛选标准
高标准的机构会对志愿者进行严苛的背景调查,包括但不限于:年龄(20-28岁)、BMI指数、隐性遗传病筛查以及受教育程度。这种定制化服务使得“配子补偿费”呈现阶梯式分布,名校毕业生或特定外貌特征的志愿者补偿金更高。
四、 广州代怀公司管理模式与后台运作
1. 孕妈的闭环式管理
一家成熟的代怀公司,其核心竞争力在于对“代妈”的管理。2026年的主流模式是“小区集中化管理”,即在广州市区或近郊租用高档公寓,由专业保姆负责膳食,并有专职医疗助理定期带队前往合作医院产检。这种闭环管理极大降低了孕期流产或私自逃跑的风险。
2. 医疗协作与实验室标准
大多数私立机构并不直接拥有手术资质,而是通过与具备资质的专科医院实验室合作,利用其先进的恒温培养箱和显微操作系统完成取卵与移植。客户在考察时,应重点关注机构合作实验室的层流级别及胚胎师的从业年限。
五、 广州本地机构介绍与风险避雷指南
1. 权威公立生殖中心推荐
- 中山大学附属第一医院: 华南地区三代技术的标杆,适合有复杂遗传病史的家庭。
- 广医三院: 拥有国内领先的生殖医学实验室,处理高龄难孕经验丰富。
- 广东省妇幼保健院: 流程规范,成功率稳定,是大多数家庭的首选。
2. 如何识别营销套路
警惕任何承诺“包生男孩”或“零风险”的宣传。虽然三代技术在理论上可以实现性别筛选,但在国内法律框架下,非医学需要的性别鉴定是违法的。正规机构通常会以“优生优育”为名进行胚胎等级评估,而非直接承诺性别。
六、 总结:给2026年准父母的建议
面对复杂的市场环境,建议准父母们:首先,明确自身预算与身体指征;其次,必须实地考察机构的办公环境与孕妈宿舍;最后,在签署合同时,务必明确各阶段付款节点及失败后的补偿条款。广州作为医疗高地,只要选择得当,实现家庭梦想的路径依然清晰。
常见问题 (FAQ)
Q1:2026年广州做试管婴儿可以报销医保吗?
A:目前广州已将部分促排药物和取卵手术纳入医保报销范围,但仅限在公立医院进行的常规治疗。涉及第三方助孕或私立机构的服务费用,目前尚不在报销范围内。
Q2:如果代妈在孕期出现意外,责任如何界定?
A:正规机构会在合同中明确“不可抗力”与“管理疏漏”的区别。若是因机构照顾不周导致的流产,通常由机构承担重新移植的费用;若是自然因素导致的早产,相关医疗费用(如保温箱费)通常由客户承担。
Q3:如何验证一家助孕公司的真实性?
A:一看营业执照的经营范围;二看是否有真实的办公场地和长期合作的医疗资源;三看其在行业内的口碑,建议通过老客户转介绍而非单纯看网络广告。
Q4:三代试管真的能保证宝宝健康吗?
A:三代技术(PGT)能筛查出绝大多数染色体异常和单基因遗传病,极大降低了出生缺陷率,但无法百分之百排除所有环境因素导致的突变,因此孕期的常规产检依然必不可少。

Tags:
转载:感谢您对网站平台的认可,以及对我们原创作品以及文章的青睐,非常欢迎各位朋友分享到个人站长或者朋友圈,但转载请说明文章出处“来源演示站”。
相关文章
- 权威代生机构与辅助生殖服务解析
- 试管长方案降调后卵泡变化及关键注意事项
- 中山供卵试管及借卵子费用详情分析
- 广州前三名生殖中心医院排名与三大供卵公司位置
- 地中海贫血夫妇生育健康宝宝的策略与助孕选择
- 广州各区供卵怀孕及代生孩子详细地址指引
- 广州代孕医院与正规卵子库选择指南
- 关注新生儿健康:先天性角膜白斑与蛋白偏低解析
- 供卵试管婴儿医院选择与费用指南
- 揭露供卵试管骗局全过程与中介陷阱
随机图文

地下供卵产业链曝光:风险与法律警示
本文探讨地下供卵和非法助孕服务的风险,涉及代生、代怀等关键词,提醒读者...
2026广州试管代怀孕价格行情与供卵代怀公司介绍
2026广州试管代怀孕价格行情与供卵代怀公司深度解析 随着医疗技术的飞速发展...
广州前三名生殖中心医院排名与三大供卵公司位置
广州前三名生殖中心医院排名与三大供卵公司位置深度解析 广州作为华南地区...
关注新生儿健康:先天性角膜白斑与蛋白偏低解析
关注新生儿健康:先天性角膜白斑与蛋白偏低解析 新生儿的健康是家庭与社会...
点击排行
 地下供卵产业链曝光:风险与法律警示
地下供卵产业链曝光:风险与法律警示- 2026广州试管代怀孕价格行情与供卵代怀公司介绍
- 广州前三名生殖中心医院排名与三大供卵公司位置
- 关注新生儿健康:先天性角膜白斑与蛋白偏低解析
- 供卵试管婴儿医院选择与费用指南
- 广州供卵试管防骗指南与成功经验分享
- 揭露供卵试管骗局全过程与中介陷阱
- 中山供卵试管及借卵子费用详情分析
- 地中海贫血夫妇生育健康宝宝的策略与助孕选择
标签云
猜你喜欢
- 权威代生机构与辅助生殖服务解析
- 试管长方案降调后卵泡变化及关键注意事项
- 中山供卵试管及借卵子费用详情分析
- 广州前三名生殖中心医院排名与三大供卵公司位置
- 地中海贫血夫妇生育健康宝宝的策略与助孕选择
- 广州各区供卵怀孕及代生孩子详细地址指引
- 广州代孕医院与正规卵子库选择指南
- 关注新生儿健康:先天性角膜白斑与蛋白偏低解析
- 供卵试管婴儿医院选择与费用指南
- 揭露供卵试管骗局全过程与中介陷阱

